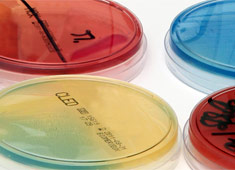

Diagnostik
Sonografie des Harntraktes einschließlich transrektalem (durch den Darm) Ultraschall der Prostata und Dopplerultraschall (Verfahren zur Prüfung der Durchgängigkeit der Arterien z. B. der Hoden oder des männlichen Gliedes)




Sprechzeiten:
| Montag | OP | 13–18 Uhr |
| Dienstag | 9–13 Uhr | 15–19 Uhr |
| Mittwoch | – | 12–16 Uhr |
| Donnerstag | 9–13 Uhr | – |
| Freitag | 9–13 Uhr | – |
Diagnostik
Sonografie des Harntraktes einschließlich transrektalem (durch den Darm) Ultraschall der Prostata und Dopplerultraschall (Verfahren zur Prüfung der Durchgängigkeit der Arterien z. B. der Hoden oder des männlichen Gliedes)

Dr. med. Thomas Stolze
Facharzt für Urologie u. Andrologie
Tel : 030 80 60 26 35
Fax : 030 80 60 26 36

Sprechzeiten:
| Montag | OP | 13 - 18 Uhr |
| Dienstag | 9 - 13 Uhr | 15 - 19 Uhr |
| Mittwoch | - | 12 - 16 Uhr |
| Donnerstag | 9 - 13 Uhr | - |
| Freitag | 9 - 13 Uhr | - |
Jetzt Termin vereinbaren: Kontakt
Dr. med. Thomas Stolze
Facharzt für Urologie u. Andrologie
Tel : 030 80 60 26 35
Fax : 030 80 60 26 36

Diagnostik
Sonografie des Harntraktes einschließlich transrektalem (durch den Darm) Ultraschall der Prostata und Dopplerultraschall (Verfahren zur Prüfung der Durchgängigkeit der Arterien z. B. der Hoden oder des männlichen Gliedes)
Sprechzeiten:
| Montag | OP | 13 - 18 Uhr |
|---|---|---|
| Dienstag | 9 - 13 Uhr | 15 - 19 Uhr |
| Mittwoch | - | 12 - 16 Uhr |
| Donnerstag | 9 - 13 Uhr | - |
| Freitag | 9 - 13 Uhr | - |



